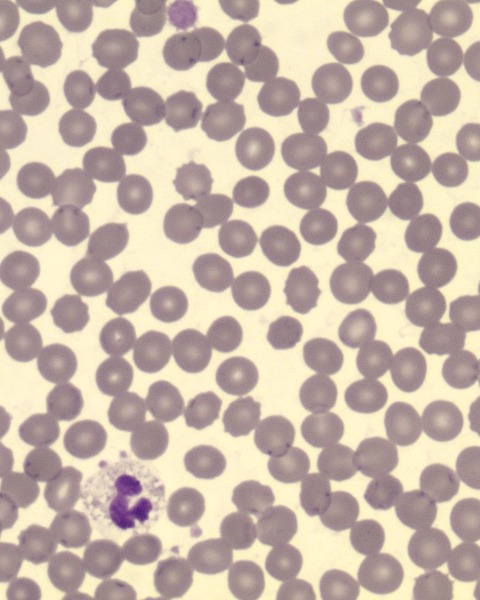

Hematopathology
(H038) Utility of Peripheral Blood Genetic Testing in the work up of idiopathic Chronic Cytopenia in Adults to identify Myeloid Disorders
Friday, November 14, 2025
9:15 AM - 10:15 AM EST
Rajan Dewar, MD., PhD., (he/him/his)
Director of Hematopathology
Detroit Medical Center, Wayne State University

